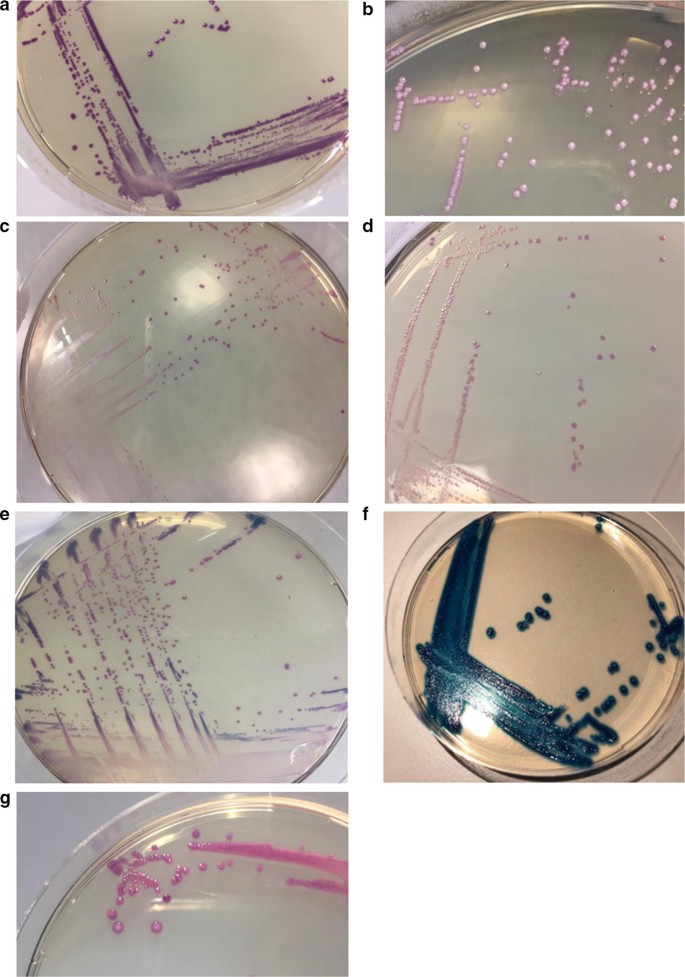
figure 1

- Research note
- Open access
- Published:
Evaluation of matrix-assisted laser desorption ionisation time-of-flight mass spectrometry (MALDI-TOF MS) for the Identification of Group B Streptococcus
BMC Research Notes volume 12, Article number: 85 (2019)
Abstract
Objective
Group B Streptococcus (GBS) is a leading cause of neonatal meningitis and sepsis worldwide. Intrapartum antibiotics given to women carrying GBS are an effective means of reducing disease in the first week of life. Rapid and reliable tests are needed to accurately identify GBS from these women for timely intrapartum antibiotic administration to prevent neonatal disease. Many laboratories now use matrix-assisted laser desorption ionisation time-of-flight mass spectrometry (MALDI-TOF MS) by direct plating or cell lysis for the identification of GBS isolates. The cell lysis step increases time to results for clinical samples and is more complex to perform. Therefore, we seek to evaluate the sensitivity and specificity of the quicker and more rapid direct plating method in identifying GBS.
Results
We directly compared swab isolates analysed by both direct plating and cell lysis method and demonstrated that direct plating has a sensitivity and specificity of 0.97 and 1, respectively, compared to an additional cell lysis step. We demonstrated that MALDI-TOF MS can be successfully used for batch processing by the direct plating method which saves time. These results are reassuring for laboratories worldwide who seek to identify GBS from swabs samples as quickly as possible.
Introduction
Group B Streptococcus (GBS or Streptococcus agalactiae) is a Gram-positive bacterium found colonising in the genitourinary and gastrointestinal tracts of approximately 20% of pregnant women [1,2,3]. Maternal colonisation is the primary source of transmission in neonatal GBS infections as the bacterium can spread in utero, or from neonatal inhalation or ingestion of contaminated vaginal fluids. Infections can cause still- and preterm-births, foetal sepsis, meningitis, pneumonia and neurodevelopmental complications in survivors of GBS meningitis [3, 4]. Intrapartum antibiotic prophylaxis (IAP) can be given to pregnant women in labour to prevent neonatal early-onset disease if GBS has been identified by swab-based screening. However, culture-based methods of GBS detection can require a long turnaround time of 3–5 days [5] from swab being taken to results being given, and a number of women will not know their diagnosis before going into labour and will therefore not receive timely IAP.
Public Health England guidelines recommend inoculating swabs in a selective enrichment broth prior to sub-culturing specimen on blood or chromogenic agar plates to detect GBS carriage [6]. Presumptive GBS colonies from agar plates should then be confirmed through antigen-specific tests, biochemical tests and/or matrix-assisted laser desorption ionisation time-of-flight mass spectrometry (MALDI-TOF MS) [7]. Antigenic or biochemical tests are less favourable than MALDI-TOF MS as they offer lower sensitivity [5] and have been shown to cross-react to give false identification [8]. MALDI-TOF MS is quick, sensitive and economical. Currently, there are two sample preparation methods for MALDI-TOF MS analysis: direct plating or a full protein extraction by cell lysis [9, 10]. The direct plating method is considered to be less complex and more rapid than the cell lysis method. MALDI-TOF MS is 100% accurate for β-haemolytic Streptococcus [11], however Bizzini et al., showed that MALDI-TOF MS identification accuracy can be influenced by preparatory methods used [12]. The use of and reliance on the accuracy of identification by MALDI-TOF MS is increasing in clinical laboratories globally [13], with Food and Drug Administration approval for MALDI-TOF MS systems and time savings well documented [14]. It is important to ascertain the optimal methodology for GBS species identification for laboratories considering the increased use of MALDI-TOF MS. In this study we describe the largest investigation of GBS isolates to date to inform microbiology laboratories guidance in the identification of GBS comparing direct plating and cell lysis MALDI-TOF MS preparatory methods.
Main text
Methods
Bacterial isolates
947 Streptococcus, Lactococcus, Aerococcus and Weissella spp. isolates were cultured from clinically diverse rectal, vaginal and nasopharyngeal swabs in skim milk, tryptone, glucose, and glycerin (STGG) from pregnant women and infants [15]. To culture the bacteria, 200 µl of STGG was inoculated in 2 ml LIM RambaQUICK StrepB (CHROMagar, France) and incubated at 37 °C in 5% CO2 for 6–24 h. 10 µl of overnight growth was plated on CHROMagar StrepB (CHROMagar, France) at 37 °C in 5% CO2 for 18–24 h. Presumptive GBS colonies with a mauve morphology were selected to undergo a confirmatory test by MALDI-TOF MS. Bacteria plated on Columbia blood agar (Oxoid, England) were incubated at 37 °C in 5% CO2 for 18–24 h.
MALDI-TOF MS preparation
Confirmation of bacterial species identification using MALDI-TOF MS were performed as previously described [11]. Briefly, for the direct colony method, a single colony was picked and spotted onto a steel target plate (Bruker Daltonics, Germany) and allowed to dry before overlaying with 1 µl of MALDI matrix (Bruker Daltonics, Germany), a solution of α-cyano-4-hydroxycinnamic acid (HCCA) dissolved in 50% acetonitrile and 2.5% trifluoroacetic acid. For the cell lysis method, 1 µl loopful of bacteria was taken and suspended in 300 µl of molecular grade water and vortexed. 900 µl of 100% ethanol was added, vortexed then centrifuged at 16,000g for 2 min. The supernatant was discarded and the pellet left to dry at room temperature. Next, the pellet was resuspended in 30 µl of 70% formic acid and 30 µl of 100% acetonitrile then centrifuged at 16,000g for 2 min. 1 µl of supernatant was spotted onto the target plate and 1 µl of MALDI matrix directly overlaid. MALDI-TOF MS was performed using MALDI Biotyper (Bruker Daltonics, Germany) according to manufacturer’s recommendations. Spectra were analysed using Bruker Biotyper software (version 4.1.70). Using the manufacture’s criteria, log scores ≥ 2.00 indicate identification to species level, scores 1.70–1.99 indicate genus identification, and scores < 1.70 were interpreted as unreliable and were repeated. Isolates were tested in duplicate and deemed reliable and correct if identification of the repeated sample was the same species.
API testing
API biochemical test strip kit (bioMérieux, USA) was used to identify the bacteria species of the nine discordant results. The test was performed following manufacturer’s instructions. Results from the tests were analysed through APIWEB software (bioMérieux, USA).
Statistical analysis
Comparisons of genus- or species-level identification using direct plating versus protein extraction method were made using McNemar’s paired test on GraphPad Prism (version 7.03). P value < 0.05 were considered statistically significant.
Results
MALDI-TOF MS sample preparation methods
We compared the direct plating method against a cell lysis method for MALDI-TOF MS analysis on 96 colonies that exhibit similar morphologies to GBS on CHROMagar from a sub-set of 33 clinically diverse swabs collected from mother-infant pairs. All isolates were identified to the genus level (log score 1.70–1.99) using either of the two methods. Cell lysis was able to identify 91/96 isolates to the species-level (log score ≥ 2.00) and direct plating identified 88/96 (Table 1). Isolates were correctly identified by both methods as Streptococcus agalactiae (n = 36), Streptococcus salivarius (n = 1), Weissella confusa (n = 2), Lactococcus garvieae (n = 45), Lactococcus lactis (n = 8) and Aerococcus viridans (n = 4). The sensitivity and specificity for direct plating compared to cell lysis were 0.97 and 1, respectively. Positive and negative predictive values for this method were 1 and 0.99, respectively.
Identification of GBS using CHROMagar and direct plating MALDI-TOF MS method
We analysed 851 rectovaginal, rectal and nasopharyngeal swabs from 155 mother-infant pairs using the direct plating method for MALDI-TOF MS analysis. These swabs had initially been identified as GBS positive by Columbia blood agar and confirmed using MALDI-TOF MS by direct plating. 842 (98.9%) isolates had the typical morphology of GBS and 9 (1.4%) isolates had morphologies not suggestive of the typical GBS appearance. The nine discordant samples had similar colony morphologies, with different colouration in some cases, to GBS on CHROMagar (Fig. 1) and were identified as GBS by the direct plating method on MALDI-TOF MS. These discrepant strains were subsequently re-analysed by API biochemical test strip kits and MALDI-TOF MS by cell lysis method as previously described [10], and were confirmed as Weissella confusa (n = 4), Streptococcus salivarius (n = 2), Aerococcus viridans (n = 2) and Enterococcus faecalis (n = 1).
Discussion
To our knowledge, this is the largest study evaluating MALDI-TOF MS preparation methods for GBS identification from clinical specimens in combination with CHROMagar. Previous studies have demonstrated MALDI-TOF MS to be a valuable tool for identification of GBS with a high level of accuracy [10, 16, 17].
Several species such as Enterococcus spp., Streptococcus bovis, Streptococcus porcinus, Streptococcus pseudoporcinus, Streptococcus salivarius, Streptococcus thoraltensis, Streptococcus anginosus, Streptococcus pyogenes and Staphylococcus spp. have been documented to develop colonies that resemble GBS on chromogenic agar compared to blood agar [5]. In our study, we found that MALDI-TOF MS incorrectly identified 9 isolates that had morphology similar to GBS on CHROMagar. However, when we compared direct plating with cell lysis, we found no difference in either approach to accurately identify GBS.
MALDI-TOF MS is a powerful tool for microbial identification, however, for some microorganisms this instrument is unable to discriminate between genus and species due to lack of reference spectra [18, 19], low identification scores [20] or low resolution of phylogenetically similar species [1]. Poor sample preparation can also influence the quality of results and care must be made to ensure sample and matrix are air-dried to prevent liquid smears and cross-contamination between spots on the target plate [12]. As MALDI-TOF MS spectra rely on the ionisation of proteins on the bacterial surface, some authors suggest that an additional cell lysis step is required for the species-level identification of Gram-positive bacteria to lyse the peptidoglycan cell wall and enable unmasking of these surface proteins to increase the protein profile [12]. This is supported by this study in which increased species level detection was achieved using cell-lysis as opposed to direct plating. Some Streptococcus species such as S. viridans [21], S. pneumoniae [22], and S. mitis [23] have been mis-identified through direct plating MALDI-TOF MS methods due to similarities in protein mass spectra. However, in our study GBS was correctly identified by both methods.
Evaluation of both preparatory methods have been studied in smaller studies for GBS [10, 16, 24, 25] demonstrating that direct plating gives high resolution in assigning species identification. In our study, we confirm that direct plating gives an accurate identification of GBS and species that resembled GBS on CHROMagar, without the requirement of a cell lysis extraction.
To conclude, the use of MALDI-TOF MS using direct plating preparatory methods is a reliable way to accurately identify GBS in a clinical diagnostic laboratory. A marginal increase in species level detection can be achieved using cell lysis but requires considerable extra effort over and above direct plating and has no overall effect on the specificity of GBS identification. Accurate bacterial species identification is key to the timely administration of IAP and can directly influence clinical care in cases with GBS that can be facilitated by MALDI-TOF MS [5]. The direct plating method is less time-consuming for large sample numbers as the application takes minutes whilst the cell lysis procedure can take half a day when batch processing. This makes direct plating more favourable in hospital diagnostic settings where rapid results are critical to determine whether a patient requires time-critical treatment, such as correctly identifying a woman requiring intrapartum antibiotic prophylaxis to prevent transmission of GBS, or to determine the best course of treatment in the case of infant GBS meningitis or sepsis.
Limitations
Although we cannot explain the reason for the nine discordant results found, API biochemical tests confirmed the isolates to be non-GBS. Since we have shown that both MALDI-TOF MS preparatory methods consistently gave reliable identification of GBS, the reason for the discordance requires further investigation. It could reflect either lack of purity of colonies on agar plate, storage of the inappropriate strain or a potential contamination during sample preparation on the target MALDI-TOF MS plate.
References
Khot PD, Fisher MA. Novel approach for differentiating Shigella species and Escherichia coli by matrix-assisted laser desorption ionization–time of flight mass spectrometry. J Clin Microbiol. 2013;51:3711–6.
Russell NJ, Seale AC, O’Driscoll M, et al. Maternal colonization with group b streptococcus and serotype distribution worldwide: systematic review and meta-analyses. Clin Infect Dis. 2017;65:S100–S111111.
Verani JR, McGee L, Schrag SJ, Division of Bacterial Diseases, NationalCenter for Immunization and Respiratory Diseases C for DC and P (CDC). Prevention of perinatal group B streptococcal disease—revised guidelines from CDC, 2010. MMWR Recomm reports Morb Mortal Wkly report Recomm reports. 2010;59:1–36.
Kohli-Lynch M, Russell NJ, Seale AC, et al. Neurodevelopmental impairment in children after Group B Streptococcal disease worldwide: systematic review and meta-analyses. Clin Infect Dis. 2017;65:S190–S199199.
Rosa-Fraile M, Spellerberg B. Reliable detection of Group B Streptococcus in the clinical laboratory. J Clin Microbiol. 2017;55:2590–8.
Public Health England (2018) SMI B 58: detection of carriage of group B streptococci - GOV.UK.
Public Health England. UK standards for microbiology Investigations identification of Streptococcus species Enterococcus species and morphologically similar organisms. London: Public Health England; 2014.
Suwantarat N, Grundy M, Rubin M, et al. Recognition of Streptococcus pseudoporcinus colonization in women as a consequence of using matrix-assisted laser desorption ionization-time of flight mass spectrometry for Group B Streptococcus Identification. J Clin Microbiol. 2015;53:3926–30.
Drevinek M, Dresler J, Klimentova J, Pisa L, Hubalek M. Evaluation of sample preparation methods for MALDI-TOF MS identification of highly dangerous bacteria. Lett Appl Microbiol. 2012;55:40–6.
Alatoom AA, Cunningham SA, Ihde SM, Mandrekar J, Patel R. Comparison of direct colony method versus extraction method for identification of Gram-positive Cocci by use of Bruker biotyper matrix-assisted laser desorption ionization-time of flight mass spectrometry. J Clin Microbiol. 2011;49:2868–73.
Lartigue M-F, Hery-Arnaud G, Haguenoer E, Domelier A-S, Schmit P-O, van der Mee-Marquet N, Lanotte P, Mereghetti L, Kostrzewa M, Quentin R. Identification of Streptococcus agalactiae isolates from various phylogenetic lineages by matrix-assisted laser desorption ionization-time of flight mass spectrometry. J Clin Microbiol. 2009;47:2284–7.
Bizzini A, Durussel C, Bille J, Greub G, Prod’hom. Performance of matrix-assisted laser desorption ionization-time of flight mass spectrometry for identification of bacterial strains routinely isolated in a clinical microbiology laboratory. J Clin Microbiol. 2010;48:1549–54.
Raoult D, Diawara S, Mediannikov O, et al. The ongoing revolution of MALDI-TOF mass spectrometry for microbiology reaches tropical Africa. Am J Trop Med Hyg. 2015;92:641–7.
Theparee T, Das S, Thomson RB. total laboratory automation and matrix-assisted laser desorption ionization-time of flight mass spectrometry improve turnaround times in the clinical microbiology laboratory: a retrospective analysis. J Clin Microbiol. 2018;56:e01242–e1317.
Le Doare K, Jarju S, Darboe S, Warburton F, Gorringe A, Heath PT, Kampmann B. Risk factors for Group B Streptococcus colonisation and disease in Gambian women and their infants. J Infect. 2016;72:283–94.
Binghuai L, Yanli S, Shuchen Z, Fengxia Z, Dong L, Yanchao C. Use of MALDI-TOF mass spectrometry for rapid identification of group B Streptococcus on chromID Strepto B agar. Int J Infect Dis. 2014;27:44–8.
Lartigue M-F, Kostrzewa M, Salloum M, Haguenoer E, Héry-Arnaud G, Domelier A-S, Stumpf S, Quentin R. Rapid detection of “highly virulent” Group B Streptococcus ST-17 and emerging ST-1 clones by MALDI-TOF mass spectrometry. J Microbiol Methods. 2011;86:262–5.
Emami K, Nelson A, Hack E, Zhang J, Green DH, Caldwell GS, Mesbahi E. MALDI-TOF mass spectrometry discriminates known species and marine environmental isolates of Pseudoalteromonas. Front Microbiol. 2016;7:104.
Lee M-R, Tsai C-J, Teng S-H, Hsueh P-R. Identification of Weissella species by matrix-assisted laser desorption/ionization time-of-flight mass spectrometry. Front Microbiol. 2015;6:1246.
Khot PD, Couturier MR, Wilson A, Croft A, Fisher MA. Optimization of matrix-assisted laser desorption ionization-time of flight mass spectrometry analysis for bacterial identification. J Clin Microbiol. 2012;50:3845–52.
van Veen SQ, Claas ECJ, Kuijper EJ. High-throughput identification of bacteria and yeast by matrix-assisted laser desorption ionization-time of flight mass spectrometry in conventional medical microbiology laboratories. J Clin Microbiol. 2010;48:900–7.
Seng P, Drancourt M, Gouriet F, La Scola B, Fournier P, Rolain JM, Raoult D. Ongoing revolution in bacteriology: routine identification of bacteria by matrix-assisted laser desorption ionization time-of-flight mass spectrometry. Clin Infect Dis. 2009;49:543–51.
De Bel A, Wybo I, Pierard D, Lauwers S, van Veen SQ, Claas ECJ, Kuijper EJ. Correct implementation of matrix-assisted laser desorption ionization-time of flight mass spectrometry in routine clinical microbiology. J Clin Microbiol. 2010;48:1991–2.
Ábrók M, Arcson Á, Lázár A, Urbán E, Deák J. Combination of selective enrichment and MALDI-TOF MS for rapid detection of Streptococcus agalactiae colonisation of pregnant women. J Microbiol Methods. 2015;114:23–5.
Moon H-W, Lee SH, Chung H-S, Lee M, Lee K. Performance of the Vitek MS matrix-assisted laser desorption ionization time-of-flight mass spectrometry system for identification of Gram-positive cocci routinely isolated in clinical microbiology laboratories. J Med Microbiol. 2013;62:1301–6.
Authors’ contributions
KT, EC and RD performed the experiments. KT carried out the data analysis and drafted the manuscript. KLD, EJ and VC conceived the original idea. KLD, EJ, VC and SG contributed to manuscript revisions. All authors read and approved the final manuscript.
Acknowledgements
We thank the microbiology laboratory at Charing Cross Hospital, Imperial College Healthcare NHS Trust London, and Public Health England Respiratory and Vaccine Preventable Bacteria Reference Unit team for the use of the MALDI-TOF MS instruments.
Competing interests
The authors declare that they have no competing interests.
Availability of data and materials
Datasets used during this study are available from the corresponding author on reasonable request.
Consent to publish
Not applicable.
Ethics approval and consent to participate
Not applicable.
Funding
KT and KLD are funded by The Bill & Melinda Gates Foundation and Thrasher Research Fund; EJ is jointly funded by Rosetrees Trust and The Stoneygate Trust. The funders had no role in study design, data collection and analysis, decision to publish, or preparation of the manuscript.
Publisher’s Note
Springer Nature remains neutral with regard to jurisdictional claims in published maps and institutional affiliations.
Author information
Authors and Affiliations
Corresponding author
Rights and permissions
Open Access This article is distributed under the terms of the Creative Commons Attribution 4.0 International License (http://creativecommons.org/licenses/by/4.0/), which permits unrestricted use, distribution, and reproduction in any medium, provided you give appropriate credit to the original author(s) and the source, provide a link to the Creative Commons license, and indicate if changes were made. The Creative Commons Public Domain Dedication waiver (http://creativecommons.org/publicdomain/zero/1.0/) applies to the data made available in this article, unless otherwise stated.
About this article
Cite this article
To, KN., Cornwell, E., Daniel, R. et al. Evaluation of matrix-assisted laser desorption ionisation time-of-flight mass spectrometry (MALDI-TOF MS) for the Identification of Group B Streptococcus. BMC Res Notes 12, 85 (2019). https://doi.org/10.1186/s13104-019-4119-1
Received:
Accepted:
Published:
DOI: https://doi.org/10.1186/s13104-019-4119-1